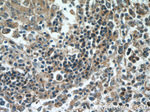
5 Lipoxygenase Antibody in Immunohistochemistry (Paraffin) (IHC (P))

Search
Proteintech
5 Lipoxygenase Monoclonal Antibody (3B1B7)
{{$productOrderCtrl.translations['antibody.pdp.commerceCard.promotion.promotions']}}
{{$productOrderCtrl.translations['antibody.pdp.commerceCard.promotion.viewpromo']}}
{{$productOrderCtrl.translations['antibody.pdp.commerceCard.promotion.promocode']}}: {{promo.promoCode}} {{promo.promoTitle}} {{promo.promoDescription}}. {{$productOrderCtrl.translations['antibody.pdp.commerceCard.promotion.learnmore']}}
产品信息
66326-1-IG
种属反应
宿主/亚型
分类
类型
克隆号
抗原
偶联物
形式
浓度
规格
纯化类型
保存液
内含物
保存条件
运输条件
产品详细信息
Immunogen sequence: MPSYTVTVA TGSQWFAGTD DYIYLSLVGS AGCSEKHLLD KPFYNDFERG AVDSYDVTVD EELGEIQLVR IEKRKYWLND DWYLKYITLK TPHGDYIEFP CYRWITGDVE VVLRDGRAKL ARDDQIHILK QHRRKELETR QKQYRWMEWN PGFPLSIDAK CHKDLPRDIQ FDSEKGVDFV LNYSKAMENL FINRFMHMFQ SSWNDFADFE KIFVKISNTI SERVMNHWQE DLMFGYQFLN GCNPVLIRRC TELPEKLPVT TEMVECSLER QLSLEQEVQQ GNIFIVDFEL LDGIDANKTD PCTLQFLAAP ICLLYKNLAN KIVPIAIQLN QIPGDENPIF LPSDAKYDWL (1-349 aa encoded by BC130332)
靶标信息
This gene encodes a protein which, with Arachidonate 5-lipoxygenase-activating protein, is required for leukotriene synthesis. Leukotrienes are arachidonic acid metabolites which have been implicated in various types of inflammatory responses, including asthma, arthritis and psoriasis. This protein localizes to the plasma membrane. Inhibitors of its function impede translocation of 5-lipoxygenase from the cytoplasm to the cell membrane and inhibit 5-lipoxygenase activation.
仅用于科研。不用于诊断过程。未经明确授权不得转售。
生物信息学
蛋白别名: 5-LO; Arachidonate 5-lipoxygenase; arachidonic acid 5-lipoxygenase; leukotriene A4 synthase; lipoxygenase; LOX-5; lox5; Polyunsaturated fatty acid 5-lipoxygenase; RP11-67C2.3
基因别名: 5-LO; 5-LOX; 5LPG; ALOX5; LOG5
UniProt ID: (Human) P09917
Entrez Gene ID: (Human) 240, (Pig) 100156205